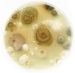

Find a Mold Specialist Now
Click or Call, Toll-Free 24/7
Basement Mold Remediation
The basement is often an ideal place for mold to grow, and basement mold remediation is necessary if you have mold growing downstairs. Removing mold from basement areas can be a big cleanup process, but it is necessary to avoid mold exposure throughout the home. Many houses have a lack of air circulation in the basement and it is common for a basement to have a higher humidity since it is below ground. These conditions create the perfect environment for mold and mildew.
Mold Cleaning in the Basement

There are a few steps that should be followed in the basement mold remediation process. Before you start removing mold from basement rooms, you need to first identify the source of the problem. It is common for mold problems to arise as a result of cracked pipes or water leaking in from outside and the source of water needs to be contained in order to prevent the mold from growing.
By using various tools and cleaning supplies you can get rid of the mold, but there are different techniques that must be used depending on the surface that you are working with. Basement mold remediation can be difficult, because the floor is usually made of cement. Many people are surprised to learn that cement is actually porous and can contain mold spores even after a deep clean. If the mold has penetrated the cement, then professional grade cleaning tools and supplies are needed in order to get rid of all of the mold spores.
When you are removing mold from basement walls, be sure to replace all sheetrock and insulation that is affected by the mold. These materials are also porous and they will hold the mold spores for extended periods of time. Any wood that is affected by the mold will need to be replaced, or can be sanded to get to the mold that has penetrated the surface. Sanding moldy wood should only be done by professionals due the the increased risk of mold exposure.

During this cleaning process, don’t forget to protect your health by wearing goggles and a breathing mask. Also, avoid contact with the skin, and wash your clothes immediately after the cleanup process is complete. Be careful about cross contamination problems, because wearing your cleanup clothes through other areas of the house may spread the mold spores.
Preventing Mold in the Basement
Once the basement mold remediation process is complete, it is important to remember that the project is not over simply by removing mold from basement areas. After the mold has been removed, it is essential that a few steps are taken in order to prevent future mold growth.
First, be sure that there is sufficient air flow in the basement; having a sufficient oxygen supply will keep the air fresh and prevent mold and mildew. Next, if there are any areas that have been damaged by water, be careful to remove and discard those materials. Any porous material should be replaced with brand new supplies. A few examples of items to watch for include carpet, drywall, ceilings, insulation, and furniture.
Once the basement mold remediation process is complete, allow the area to completely dry before replacing the drywall, carpet, and furniture. Removing mold from basement areas takes some time, because if the basement is not completely dry it may cause mold to begin growing again. It is a good idea to use fans and dehumidifiers to remove all of the moisture before refinishing the basement.
We recommend that you work with a professional mold removal company. They will have all of the knowledge, equipment and supplies that are needed for the cleanup process. They will also be able to make any necessary repairs so that your mold problem will not return in the future. Remember, if even a little mold is missed, it will just grow back and eventually spread to the rest of your home. Because of everything that’s involved in the cleanup process, we find that it is often cheaper to hire a professional company and allow them to take care of everything for you.
Finding a Mold Removal Specialist
Follow This Link to find a list of mold removal specialists near you. These mold removal specialists offer free consultations, so they will visit your home and assess the situation at no cost to you. Even if you end up deciding to handle the cleanup yourself, you can get valuable advice from a free consultation with a professional, including important safety tips.
Mold in a basement after a flood
Return From Basement Mold Remediation To Our Main Basement Mold Removal Page
Black Mold Health Symptoms Home Page